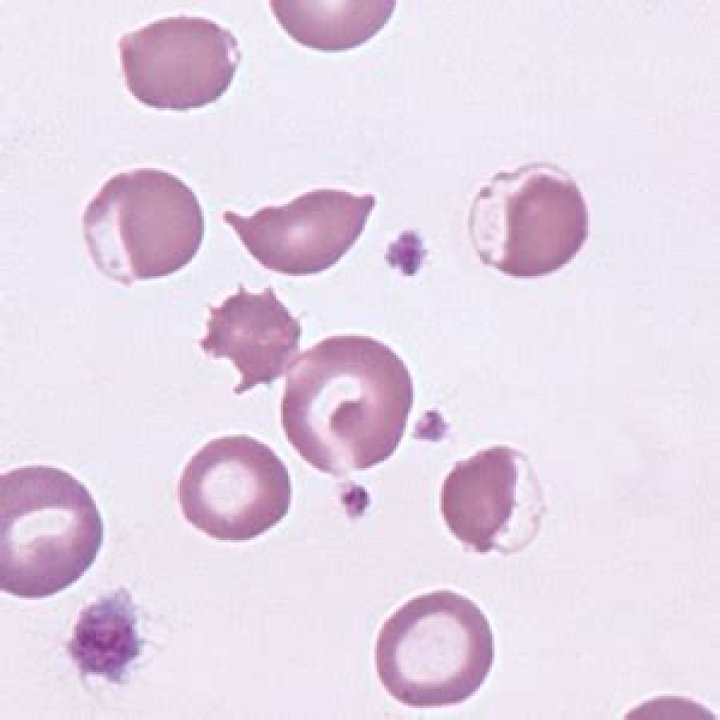

Essential Insight into Eccentrocytes: A Comprehensive Examination
Eccentrocytes are a unique type of red blood cell that have intrigued medical professionals and researchers alike due to their distinctive appearance and the conditions they signify. These cells, also known as "bite cells" or "hemighost cells," are characterized by their crescent-shaped or half-moon morphology. The presence of eccentrocytes in a blood smear can indicate oxidative damage to the red blood cells, often resulting from various pathological conditions or oxidative stress. Understanding the formation, significance, and implications of eccentrocytes is crucial for healthcare providers as they can serve as vital indicators of underlying health issues.
The morphology of eccentrocytes is a result of oxidative stress leading to the denaturation of hemoglobin. This process causes the hemoglobin to move to one side of the cell, creating the distinctive crescent shape. Such stress can be caused by numerous factors, including exposure to certain drugs, toxins, or underlying diseases like glucose-6-phosphate dehydrogenase (G6PD) deficiency or hereditary spherocytosis. The identification and analysis of eccentrocytes are important in diagnosing and managing these conditions. By recognizing the presence of these cells, clinicians can take appropriate measures to address the causative factors and mitigate potential complications.
In the realm of hematology, eccentrocytes occupy a significant position due to their diagnostic value. Their appearance in blood tests can aid in the detection of diseases that might otherwise go unnoticed. As research progresses, the understanding of eccentrocytes continues to evolve, providing deeper insights into their role in medical diagnostics. This comprehensive examination of eccentrocytes aims to shed light on their formation, clinical significance, and the advancements in research surrounding these fascinating cells. By exploring the intricacies of eccentrocytes, we can better appreciate their role in the broader context of medical science and patient care.
Table of Contents
- The Biology of Eccentrocytes
- Formation and Morphology
- Clinical Significance
- Diagnostic Process
- Conditions Associated with Eccentrocytes
- Treatment Options
- Research Advancements
- Role in Modern Diagnostics
- Potential Risks and Complications
- Preventive Measures
- Case Studies
- Laboratory Techniques for Identification
- Future Prospects
- Frequently Asked Questions
- Conclusion
The Biology of Eccentrocytes
Eccentrocytes are a type of erythrocyte, or red blood cell, that exhibits a distinct morphological alteration due to oxidative stress. Understanding their biology begins with understanding the structure and function of normal red blood cells. Erythrocytes are responsible for transporting oxygen from the lungs to the body's tissues and returning carbon dioxide from the tissues to the lungs for exhalation. This process is facilitated by hemoglobin, a protein within the red blood cells that binds to oxygen and carbon dioxide.
The cell membrane of erythrocytes is highly flexible, allowing these cells to traverse through narrow capillaries. Red blood cells also possess a biconcave shape, which increases their surface area for gas exchange. However, when oxidative stress occurs, the structural integrity of the red blood cell is compromised, leading to the formation of eccentrocytes. The oxidative damage results in the denaturation and precipitation of hemoglobin, causing it to shift to one side of the cell. This shift leads to the characteristic appearance of eccentrocytes, where one side appears empty and the other is densely packed with hemoglobin.
The formation of eccentrocytes can be triggered by various oxidative agents, including certain medications, toxins, and metabolic imbalances. These agents cause the generation of reactive oxygen species (ROS), which are highly reactive molecules that can damage cellular structures, including lipids, proteins, and nucleic acids. In red blood cells, ROS primarily target the cell membrane and hemoglobin, leading to the formation of eccentrocytes.
Beyond their distinct morphology, eccentrocytes also exhibit altered functionality. Their compromised structure can impair the red blood cell's ability to transport oxygen effectively, leading to symptoms of anemia in affected individuals. Moreover, the presence of eccentrocytes often indicates an underlying pathological condition, making their identification important in clinical diagnostics.
Formation and Morphology
The formation of eccentrocytes is primarily attributed to oxidative damage to the red blood cells. This damage disrupts the normal structure and function of erythrocytes, leading to their characteristic morphological changes. Understanding the formation and morphology of eccentrocytes involves examining the biochemical processes that lead to oxidative stress and the subsequent structural alterations in the cells.
Oxidative stress is a state where there is an imbalance between the production of reactive oxygen species (ROS) and the body's ability to neutralize them with antioxidants. ROS are byproducts of normal cellular metabolism, but their levels can increase significantly due to external factors like exposure to toxins, radiation, or certain drugs. When ROS levels become excessive, they can cause damage to various cellular components, including lipids, proteins, and DNA.
In the case of red blood cells, oxidative damage primarily affects the cell membrane and hemoglobin. The cell membrane is composed of a lipid bilayer that provides structural support and maintains the cell's shape. ROS can peroxidize the lipids in the membrane, leading to its destabilization and increased susceptibility to damage. This damage alters the cell's ability to maintain its biconcave shape, resulting in the formation of eccentrocytes.
Hemoglobin, the protein responsible for oxygen transport, is also vulnerable to oxidative damage. ROS can cause the oxidation of hemoglobin, leading to its denaturation and precipitation within the cell. This process causes hemoglobin to migrate to one side of the cell, creating the characteristic crescent shape of eccentrocytes. The other side of the cell appears empty, as the hemoglobin has shifted away from it.
Several conditions and factors can contribute to the formation of eccentrocytes. These include genetic disorders like glucose-6-phosphate dehydrogenase (G6PD) deficiency, which impairs the red blood cell's ability to counteract oxidative stress. Additionally, exposure to certain drugs, such as sulfa drugs or dapsone, can induce oxidative stress and lead to the formation of eccentrocytes. Other contributing factors include infections, metabolic disorders, and exposure to environmental toxins.
Clinical Significance
The presence of eccentrocytes in a blood smear is clinically significant, as it often indicates underlying oxidative stress or pathological conditions that require further investigation. Eccentrocytes serve as important diagnostic markers, helping healthcare providers identify and manage various health issues. Their identification can provide valuable insights into the patient's overall health and guide the diagnostic process.
One of the primary clinical implications of eccentrocytes is their association with oxidative stress. Oxidative stress is a common feature in many diseases and conditions, including chronic inflammation, cardiovascular diseases, diabetes, and neurodegenerative disorders. By identifying eccentrocytes, clinicians can gain insights into the oxidative status of the patient and assess the need for further evaluation or intervention.
Eccentrocytes are also associated with specific genetic disorders, such as glucose-6-phosphate dehydrogenase (G6PD) deficiency. This genetic condition leads to a reduced ability of red blood cells to protect themselves from oxidative damage, resulting in the formation of eccentrocytes. Identifying eccentrocytes in patients with G6PD deficiency is crucial for managing the condition, as it helps prevent hemolytic episodes that can be triggered by certain drugs or foods.
In addition to genetic disorders, the presence of eccentrocytes can be indicative of exposure to certain medications or toxins. Drugs that induce oxidative stress, such as sulfa drugs or dapsone, can lead to the formation of eccentrocytes. Similarly, exposure to environmental toxins, such as lead or certain industrial chemicals, can result in oxidative damage to red blood cells and the appearance of eccentrocytes.
The identification of eccentrocytes in a blood smear can also aid in the diagnosis of other hematological disorders. For instance, hereditary spherocytosis is a condition characterized by the presence of abnormal red blood cells, including eccentrocytes. Recognizing these cells can help differentiate hereditary spherocytosis from other types of hemolytic anemia and guide appropriate management strategies.
Diagnostic Process
The diagnostic process for identifying eccentrocytes involves a combination of laboratory tests, clinical evaluation, and a thorough understanding of the patient's medical history. The presence of eccentrocytes in a blood smear is often an incidental finding, but their identification can provide valuable information for diagnosing underlying conditions.
The initial step in the diagnostic process is the examination of a peripheral blood smear. A blood smear is a laboratory test where a drop of blood is spread thinly onto a glass slide and stained to visualize the different blood cell types. Under a microscope, eccentrocytes can be identified by their distinctive morphology, characterized by a crescent or half-moon shape with one side densely packed with hemoglobin and the other appearing empty.
Once eccentrocytes are identified, further laboratory tests are conducted to determine the underlying cause of their formation. These tests may include a complete blood count (CBC) to assess overall blood cell counts, hemoglobin levels, and red blood cell indices. Additionally, tests to evaluate oxidative stress markers, such as glutathione levels or reactive oxygen species (ROS) assays, may be performed to assess the oxidative status of the patient.
In cases where a specific genetic disorder is suspected, such as glucose-6-phosphate dehydrogenase (G6PD) deficiency, genetic testing may be conducted to confirm the diagnosis. G6PD deficiency is a common genetic disorder that impairs the red blood cell's ability to counteract oxidative stress, leading to the formation of eccentrocytes. Genetic testing can help identify mutations in the G6PD gene and guide appropriate management strategies.
The clinical evaluation of the patient is also an essential component of the diagnostic process. A thorough medical history, including a review of medications, exposure to toxins, and any underlying health conditions, can provide valuable insights into the potential causes of oxidative stress. Additionally, a physical examination may reveal signs and symptoms associated with specific conditions, such as jaundice or anemia, which can further guide the diagnostic process.
Conditions Associated with Eccentrocytes
The presence of eccentrocytes in a blood smear can be associated with a variety of conditions, ranging from genetic disorders to environmental exposures. Understanding these associated conditions is crucial for accurate diagnosis and management of the underlying health issues.
One of the most well-known conditions associated with eccentrocytes is glucose-6-phosphate dehydrogenase (G6PD) deficiency. G6PD deficiency is a genetic disorder that affects the red blood cell's ability to counteract oxidative stress. This condition is more common in certain populations, such as those of African, Mediterranean, or Asian descent. Individuals with G6PD deficiency are susceptible to hemolytic anemia, especially when exposed to certain drugs, foods, or infections that induce oxidative stress.
Another condition associated with eccentrocytes is hereditary spherocytosis. This genetic disorder is characterized by the presence of abnormal red blood cells, including spherocytes and eccentrocytes. Hereditary spherocytosis is caused by defects in proteins that maintain the red blood cell's structural integrity, leading to their premature destruction in the spleen. The identification of eccentrocytes in patients with hereditary spherocytosis can aid in differentiating this condition from other types of hemolytic anemia.
Exposure to certain drugs or toxins can also lead to the formation of eccentrocytes. Medications that induce oxidative stress, such as sulfa drugs, dapsone, or certain antibiotics, can result in oxidative damage to red blood cells and the appearance of eccentrocytes. Similarly, exposure to environmental toxins, such as lead or industrial chemicals, can cause oxidative stress and the formation of eccentrocytes.
Infections can also contribute to the formation of eccentrocytes. Certain infections, particularly those caused by bacteria or viruses that produce oxidative stress as part of their pathogenic mechanisms, can lead to the appearance of eccentrocytes in the blood. Identifying these cells in the context of an infection can provide valuable insights into the severity of the oxidative stress and guide appropriate management strategies.
Treatment Options
The treatment options for conditions associated with eccentrocytes depend on the underlying cause of their formation. Addressing the root cause of oxidative stress is essential for effectively managing the condition and preventing further damage to red blood cells.
In cases where eccentrocytes are associated with glucose-6-phosphate dehydrogenase (G6PD) deficiency, the primary treatment strategy involves avoiding triggers that can induce hemolytic episodes. This includes avoiding certain medications, foods, and environmental exposures that can cause oxidative stress. Additionally, individuals with G6PD deficiency may require supportive care during hemolytic episodes, such as blood transfusions or administration of oxygen, to manage symptoms and prevent complications.
For conditions like hereditary spherocytosis, treatment may involve managing symptoms and preventing complications. In some cases, splenectomy, the surgical removal of the spleen, may be recommended to reduce the destruction of abnormal red blood cells and alleviate symptoms of anemia. Additionally, folic acid supplementation may be prescribed to support red blood cell production and prevent folate deficiency.
When eccentrocytes are associated with drug-induced oxidative stress, discontinuing the offending medication is essential to prevent further damage to red blood cells. Alternative medications that do not induce oxidative stress may be prescribed to manage the underlying condition. Additionally, supportive care, such as blood transfusions or administration of antioxidants, may be provided to manage symptoms and promote recovery.
In cases where eccentrocytes are associated with environmental toxin exposure, removing the source of exposure is crucial for preventing further oxidative damage. This may involve environmental remediation, workplace safety measures, or lifestyle modifications to reduce exposure to toxins. Additionally, supportive care and monitoring may be necessary to manage symptoms and prevent complications.
Research Advancements
Research advancements in the field of hematology have provided valuable insights into the formation, significance, and implications of eccentrocytes. These advancements have enhanced our understanding of the mechanisms underlying oxidative stress, the identification of eccentrocytes in clinical diagnostics, and the development of targeted treatment strategies.
One area of research that has contributed to our understanding of eccentrocytes is the study of oxidative stress and its impact on red blood cells. Researchers have identified various oxidative agents, both endogenous and exogenous, that can induce oxidative stress and lead to the formation of eccentrocytes. This research has also highlighted the role of genetic factors, such as glucose-6-phosphate dehydrogenase (G6PD) deficiency, in predisposing individuals to oxidative damage and the formation of eccentrocytes.
Advancements in laboratory techniques have also improved the identification and analysis of eccentrocytes. High-resolution imaging technologies, such as scanning electron microscopy and advanced staining methods, have allowed for more precise visualization of eccentrocytes' morphology. Additionally, the development of automated hematology analyzers has facilitated the rapid and accurate detection of eccentrocytes in blood samples, enhancing the efficiency of clinical diagnostics.
Research has also explored the potential therapeutic interventions for managing conditions associated with eccentrocytes. Studies have investigated the use of antioxidants, such as vitamin E or N-acetylcysteine, to mitigate oxidative stress and protect red blood cells from damage. Additionally, research into gene therapy and genetic screening has shown promise in identifying individuals at risk for conditions like G6PD deficiency and developing targeted treatment strategies.
Furthermore, research has focused on understanding the broader implications of eccentrocytes in medical diagnostics. The presence of eccentrocytes in a blood smear can serve as a valuable diagnostic marker for various conditions, including genetic disorders, drug-induced oxidative stress, and environmental toxin exposure. By studying the significance of eccentrocytes in different clinical contexts, researchers have contributed to the development of diagnostic algorithms and guidelines for their interpretation.
Role in Modern Diagnostics
Eccentrocytes play a significant role in modern diagnostics, serving as important markers for identifying oxidative stress and underlying pathological conditions. Their presence in a blood smear provides valuable information for healthcare providers, aiding in the diagnosis and management of various health issues.
In the context of genetic disorders, the identification of eccentrocytes can aid in diagnosing conditions like glucose-6-phosphate dehydrogenase (G6PD) deficiency. G6PD deficiency is a common genetic disorder that impairs the red blood cell's ability to counteract oxidative stress, leading to the formation of eccentrocytes. By recognizing these cells in a blood smear, clinicians can confirm the diagnosis and implement appropriate management strategies to prevent hemolytic episodes.
Eccentrocytes are also valuable markers for drug-induced oxidative stress. Certain medications, such as sulfa drugs or dapsone, can induce oxidative damage to red blood cells, resulting in the formation of eccentrocytes. Identifying these cells in patients taking these medications can prompt healthcare providers to reevaluate the treatment regimen and consider alternative therapies that do not induce oxidative stress.
In cases of environmental toxin exposure, the presence of eccentrocytes can indicate oxidative damage and guide further investigation into potential sources of exposure. Environmental toxins, such as lead or industrial chemicals, can cause oxidative stress and contribute to the formation of eccentrocytes. By identifying these cells, clinicians can take appropriate measures to address the source of exposure and implement strategies to mitigate further damage.
Additionally, eccentrocytes can serve as indicators of oxidative stress in various disease states. Chronic inflammation, cardiovascular diseases, diabetes, and neurodegenerative disorders are all associated with oxidative stress and the formation of eccentrocytes. Recognizing these cells in a blood smear can provide valuable insights into the oxidative status of the patient and guide further evaluation or intervention.
Potential Risks and Complications
The presence of eccentrocytes in a blood smear can be associated with potential risks and complications, depending on the underlying cause of their formation. Understanding these risks is essential for managing the condition and preventing further damage to red blood cells.
One of the primary risks associated with eccentrocytes is the potential for hemolytic anemia. Hemolytic anemia occurs when red blood cells are destroyed at a faster rate than they can be produced, leading to a deficiency of red blood cells in the body. This condition can result in symptoms such as fatigue, weakness, jaundice, and shortness of breath. Identifying and addressing the underlying cause of eccentrocytes is crucial for preventing hemolytic anemia and its associated complications.
In cases where eccentrocytes are associated with genetic disorders, such as glucose-6-phosphate dehydrogenase (G6PD) deficiency or hereditary spherocytosis, there may be additional risks related to the specific condition. For instance, individuals with G6PD deficiency are at risk for hemolytic episodes when exposed to certain drugs, foods, or infections that induce oxidative stress. Proper management and avoidance of triggers are essential for preventing these episodes and their complications.
Drug-induced oxidative stress can also pose risks to patients, particularly if left unaddressed. Certain medications can cause oxidative damage to red blood cells, leading to the formation of eccentrocytes and the potential for hemolytic anemia. Discontinuing the offending medication and considering alternative therapies are crucial steps in managing this risk and preventing further damage to red blood cells.
Exposure to environmental toxins can also result in potential risks and complications. Toxins that induce oxidative stress can cause damage to red blood cells and contribute to the formation of eccentrocytes. Identifying and addressing the source of exposure is essential for preventing further oxidative damage and mitigating complications associated with the toxins.
Additionally, the presence of eccentrocytes may indicate underlying health conditions associated with oxidative stress, such as chronic inflammation, cardiovascular diseases, or neurodegenerative disorders. Recognizing these cells in a blood smear can prompt further evaluation and intervention to address the underlying condition and manage associated risks.
Preventive Measures
Preventive measures for conditions associated with eccentrocytes focus on minimizing oxidative stress and addressing the underlying causes of their formation. Implementing these measures can help reduce the risk of complications and promote overall health and well-being.
For individuals with genetic disorders like glucose-6-phosphate dehydrogenase (G6PD) deficiency, avoiding triggers that can induce hemolytic episodes is a key preventive strategy. This includes avoiding certain medications, foods, and environmental exposures that can cause oxidative stress. Educating patients and caregivers about potential triggers and providing guidance on alternative therapies can help prevent hemolytic episodes and their associated complications.
In cases where eccentrocytes are associated with drug-induced oxidative stress, healthcare providers can take preventive measures by prescribing medications that do not induce oxidative damage. Regular monitoring and evaluation of patients taking medications known to cause oxidative stress can help identify early signs of oxidative damage and guide appropriate interventions.
Preventive measures for environmental toxin exposure involve identifying and addressing the source of exposure. This may include environmental remediation, workplace safety measures, or lifestyle modifications to reduce exposure to toxins. Implementing protective measures, such as personal protective equipment or air purification systems, can also help minimize the risk of oxidative damage.
Additionally, promoting a healthy lifestyle that includes a balanced diet, regular exercise, and stress management can help reduce oxidative stress and support overall health. A diet rich in antioxidants, such as fruits, vegetables, and whole grains, can help neutralize reactive oxygen species (ROS) and protect red blood cells from oxidative damage. Regular exercise and stress management techniques, such as meditation or yoga, can also help reduce oxidative stress and promote overall well-being.
Regular medical check-ups and screenings can also play a role in preventing conditions associated with eccentrocytes. Routine blood tests and health assessments can help identify early signs of oxidative stress and guide appropriate interventions. Additionally, genetic screening for conditions like G6PD deficiency can help identify individuals at risk and implement preventive measures to reduce the risk of complications.
Case Studies
Case studies provide valuable insights into the clinical presentation, diagnosis, and management of conditions associated with eccentrocytes. These real-life examples illustrate the complexity of these conditions and highlight the importance of a comprehensive approach to diagnosis and treatment.
Case Study 1: A 35-year-old male presented to the emergency department with symptoms of fatigue, jaundice, and dark-colored urine. Laboratory tests revealed the presence of eccentrocytes in the blood smear, along with elevated bilirubin levels and low hemoglobin levels. The patient had a history of glucose-6-phosphate dehydrogenase (G6PD) deficiency, and a recent history of taking a sulfa drug for a urinary tract infection. The diagnosis of drug-induced hemolytic anemia due to G6PD deficiency was made. The sulfa drug was discontinued, and the patient received supportive care, including blood transfusions and administration of oxygen. The patient's symptoms improved, and he was discharged with instructions to avoid medications that can induce oxidative stress.
Case Study 2: A 10-year-old female was referred to the hematology clinic for evaluation of anemia. Laboratory tests revealed the presence of eccentrocytes in the blood smear, along with elevated reticulocyte counts and low hemoglobin levels. The patient had a family history of hereditary spherocytosis, and genetic testing confirmed the diagnosis. The patient was managed with folic acid supplementation and regular monitoring of blood counts. Due to recurrent episodes of anemia, a splenectomy was performed to reduce the destruction of abnormal red blood cells. The patient's anemia improved post-splenectomy, and she continued to receive regular follow-up care.
Case Study 3: A 45-year-old male presented to the clinic with symptoms of fatigue, weakness, and shortness of breath. Laboratory tests revealed the presence of eccentrocytes in the blood smear, along with elevated levels of reactive oxygen species (ROS) and low glutathione levels. The patient had a history of occupational exposure to industrial chemicals, including lead. The diagnosis of oxidative stress-induced hemolytic anemia due to environmental toxin exposure was made. The patient was advised to reduce exposure to the chemicals and received supportive care, including antioxidants and blood transfusions. The patient's symptoms improved with intervention, and he continued to receive regular monitoring for potential complications.
Laboratory Techniques for Identification
The identification of eccentrocytes in a blood smear is a critical component of the diagnostic process for conditions associated with oxidative stress and red blood cell damage. Laboratory techniques play a crucial role in detecting and analyzing these cells, providing valuable information for clinical diagnosis and management.
The primary laboratory technique for identifying eccentrocytes is the examination of a peripheral blood smear. A blood smear involves spreading a drop of blood thinly onto a glass slide and staining it to visualize the different blood cell types. The stained slide is then examined under a microscope to assess the morphology of the red blood cells. Eccentrocytes can be identified by their distinctive crescent or half-moon shape, with one side densely packed with hemoglobin and the other appearing empty.
Several staining methods can be used to enhance the visualization of eccentrocytes in a blood smear. Wright-Giemsa stain is a commonly used staining technique that provides good contrast and detail for identifying red blood cell morphology. Additionally, supravital stains, such as brilliant cresyl blue or new methylene blue, can be used to highlight reticulocytes and other immature red blood cells that may be present alongside eccentrocytes.
In addition to manual microscopy, automated hematology analyzers have become valuable tools for detecting eccentrocytes in blood samples. These analyzers use advanced imaging and pattern recognition algorithms to identify and classify different blood cell types, including eccentrocytes. Automated analysis can enhance the efficiency and accuracy of the diagnostic process, allowing for rapid identification of eccentrocytes and prompt clinical intervention.
Further laboratory tests may be conducted to assess the underlying cause of eccentrocytes and evaluate the patient's oxidative status. These tests may include a complete blood count (CBC) to assess overall blood cell counts and red blood cell indices, as well as tests to measure oxidative stress markers, such as glutathione levels or reactive oxygen species (ROS) assays. Genetic testing may also be performed to identify specific genetic disorders, such as glucose-6-phosphate dehydrogenase (G6PD) deficiency, that predispose individuals to oxidative damage and the formation of eccentrocytes.
Future Prospects
The field of hematology continues to evolve, with ongoing research and advancements providing new insights into the formation, significance, and implications of eccentrocytes. These developments hold promise for improving the diagnosis and management of conditions associated with oxidative stress and red blood cell damage.
One area of future research is the development of targeted therapies for managing conditions associated with eccentrocytes. Advances in pharmacogenomics and personalized medicine have opened new avenues for tailoring treatments to individual patients based on their genetic profiles. This approach has the potential to improve treatment outcomes and minimize the risk of complications for patients with genetic disorders like glucose-6-phosphate dehydrogenase (G6PD) deficiency.
Additionally, ongoing research into the mechanisms of oxidative stress and its impact on red blood cells is expected to lead to the development of novel therapeutic interventions. The identification of new oxidative stress markers and the exploration of antioxidant therapies hold promise for mitigating oxidative damage and protecting red blood cells from damage.
Advancements in laboratory techniques are also anticipated to enhance the identification and analysis of eccentrocytes. The integration of artificial intelligence and machine learning algorithms into automated hematology analyzers has the potential to improve the accuracy and efficiency of eccentrocyte detection. These technologies can provide valuable insights into red blood cell morphology and guide clinical decision-making.
Furthermore, research into the broader implications of eccentrocytes in medical diagnostics is expected to continue. The presence of eccentrocytes in a blood smear can serve as a valuable diagnostic marker for various conditions, including genetic disorders, drug-induced oxidative stress, and environmental toxin exposure. By studying the significance of eccentrocytes in different clinical contexts, researchers can contribute to the development of diagnostic algorithms and guidelines for their interpretation.
Frequently Asked Questions
1. What are eccentrocytes?
Eccentrocytes are a type of red blood cell characterized by a crescent-shaped or half-moon morphology due to oxidative damage. They are often associated with oxidative stress and can indicate underlying pathological conditions.
2. How are eccentrocytes formed?
Eccentrocytes are formed as a result of oxidative stress, which leads to the denaturation of hemoglobin within the red blood cell. This causes the hemoglobin to migrate to one side of the cell, creating the distinctive crescent shape.
3. What conditions are associated with eccentrocytes?
Conditions associated with eccentrocytes include glucose-6-phosphate dehydrogenase (G6PD) deficiency, hereditary spherocytosis, drug-induced oxidative stress, and environmental toxin exposure. They can also be indicative of chronic inflammation and other oxidative stress-related disorders.
4. How are eccentrocytes diagnosed?
The diagnosis of eccentrocytes involves examining a peripheral blood smear under a microscope to identify their distinctive morphology. Further laboratory tests may be conducted to assess oxidative stress markers and evaluate the underlying cause of their formation.
5. What are the treatment options for conditions associated with eccentrocytes?
Treatment options depend on the underlying cause of eccentrocytes. For genetic disorders like G6PD deficiency, avoiding oxidative stress triggers is essential. Drug-induced oxidative stress may require discontinuing the offending medication. Supportive care and antioxidant therapies may also be used to manage symptoms and promote recovery.
6. Can eccentrocytes be prevented?
Preventive measures focus on minimizing oxidative stress and addressing the underlying causes of eccentrocyte formation. This may involve avoiding oxidative stress triggers, prescribing alternative medications, reducing exposure to environmental toxins, and promoting a healthy lifestyle.
Conclusion
Eccentrocytes are a fascinating and clinically significant type of red blood cell that provide valuable insights into the oxidative status of patients and the underlying pathological conditions they may signify. Their unique morphology and association with oxidative stress make them important markers for identifying various health issues, from genetic disorders to environmental exposures.
The presence of eccentrocytes in a blood smear serves as a valuable diagnostic tool for healthcare providers, guiding the evaluation and management of conditions associated with oxidative stress. Understanding the formation, significance, and implications of eccentrocytes is crucial for accurate diagnosis and effective treatment of these conditions.
Ongoing research and advancements in the field of hematology continue to shed light on the mechanisms underlying oxidative stress and the role of eccentrocytes in medical diagnostics. As our understanding of these processes evolves, new therapeutic interventions and diagnostic algorithms are expected to improve patient outcomes and enhance the management of conditions associated with eccentrocytes.
By recognizing the significance of eccentrocytes and implementing preventive measures, healthcare providers can address the underlying causes of oxidative stress and reduce the risk of complications. The study of eccentrocytes not only enhances our understanding of red blood cell biology but also contributes to the broader field of medical science and patient care.



